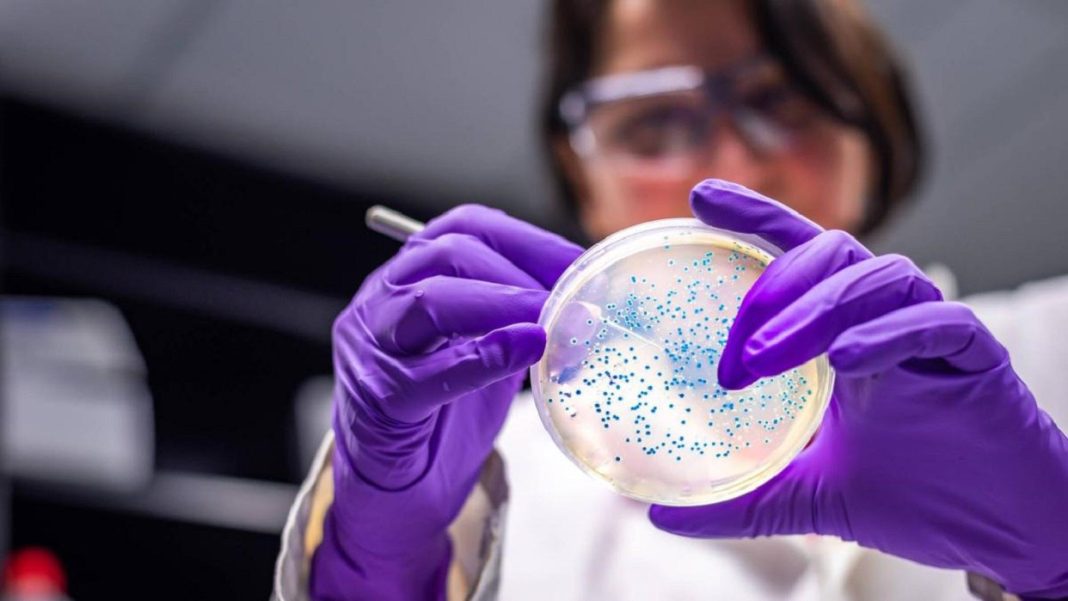

La Organización Mundial de la Salud, OMS, alertó nuevamente sobre el brote de oropouche especialmente en tres países y un territorio: Ecuador, Guyana, Panamá e Islas Caimán, en donde se han notificado casos confirmados de enfermedad por el virus.
También se han notificado casos importados de Oropouche de Canadá, Estados Unidos de América y países de la Región de Europa. “Hasta el 25 de noviembre de 2024, se han notificado un total de 11 634 casos confirmados de Oropouche, incluidas dos muertes, en la Región de las Américas, en diez países y un territorio: Bolivia (Estado Plurinacional de), Brasil, Canadá, Islas Caimán, Colombia, Cuba, Ecuador, Estados Unidos de América, Guyana, Panamá y Perú”, informó la OMS.
La Organización indicó que considera que el riesgo general para la salud pública que plantea este virus es alto en la región, pero bajo a nivel mundial. “Ante el inicio de la temporada de arbovirus en la región, la OMS insta a los países en riesgo a reforzar la vigilancia epidemiológica y entomológica y las medidas preventivas en la población”, explicó la Organización.
Debido al esparcimiento geográfico del virus y vías de transmisión, incluida la transmisión vertical, que podrían afectar a la población general como a grupos vulnerables, como las mujeres embarazadas, sus fetos y los recién nacidos.
Entre el 1 de enero y el 25 de noviembre de este año, se han notificado 11.634 casos confirmados de Oropouche y dos fallecimientos en el continente: “Bolivia (Estado Plurinacional de) (356 casos), Brasil (9563 casos, incluidas dos muertes), Canadá (dos casos importados), Islas Caimán (un caso importado), Colombia (74 casos), Cuba (603 casos), Ecuador (dos casos), Guyana (dos casos), Panamá (un caso), Perú (936 casos) y Estados Unidos de América (94 casos importados). Además, se han notificado casos importados de Oropouche en países de la Región de Europa (30 casos) (1)”, informó la OMS.
En Brasil y Cuba la OMS encontró casos y consecuencias de transmisión vertical de la infección por Oropouche. Brasil ha confirmado tres casos de transmisión vertical, entre ellos dos casos de muerte fetal y un caso de anomalía congénita en el producto, además se están investigando 15 muertes fetales, cinco abortos espontáneos y tres casos de anomalías congénitas.
Oropouche en Colombia
Entre el 1 de enero y el 5 de octubre de 2024, se han notificado 74 casos confirmados de Oropouche en tres departamentos: Amazonas (70 casos), Caquetá (1 caso) y Meta (1 caso); en dos casos personas llegadas de Tabatinga, Brasil, tenían el virus.
“Estos casos se identificaron mediante una estrategia retrospectiva de búsqueda de casos de laboratorio implementada en 2024 por el Instituto Nacional de Salud de Colombia basada en la vigilancia del dengue (38 casos) y mediante la investigación de casos de síndrome febril (36 casos)”, añadió la OMS.
En el 51,4%; 38 de los casos las portadoras fueron mujeres y el grupo de edad con mayor número de casos fue el de 10 a 19 años, con el 36,5% de los casos. No se han presentado muertes que pudieran estar asociadas a la infección por OROV.
Cabe resaltar que hasta el 3 de octubre de 2024 se han identificado dos casos de Oropouche en mujeres embarazadas, ambas de Leticia, de 18 años (inicio de síntomas a las 29 semanas de gestación) y 22 años (inicio de síntomas a las 34 semanas de gestación), respectivamente. “Ambas evolucionaron favorablemente y sus hijos nacieron sin complicaciones. Hasta la fecha, ninguno de los lactantes presenta evidencia de anomalías congénitas, síndromes neurológicos o trastornos del neurodesarrollo”, detalló la OMS.
Con información de agencias.-